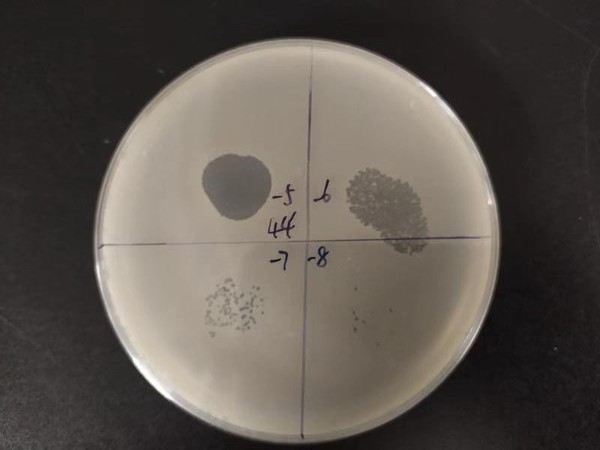

当地时间12月2日,万象城awcsport官网资源与环境科学学院沈其荣教授带领的土壤微生物与有机肥团队微生态与根际健康实验室在利用噬菌体定向调控土壤菌群-防控土传青枯病领域取得重要进展,成果以“Phage combination therapies for bacterial wilt disease in tomato”为题发表在国际顶级学术期刊《自然生物技术》(Naturebiotechnology,IF5y=45.12)。该成果揭示噬菌体不仅可以“专性猎杀”和“精准靶向”病原菌,降低其生存竞争能力;同时还能够重新调整根际土壤菌群的结构,恢复群落多样性,增加群落中拮抗有益菌的丰度。
近些年,集约化农业发展中的不合理措施,如化肥农药的持续过量投入以及经济作物的单一连作等,导致土壤微生物群落结构严重失衡,生态功能急剧削弱。土壤养分周转不畅、污染难以消解、土传病害频发就是土壤微生态失衡重要证据,这些也是农业资源与环境领域亟待解决的难题。“土壤不健康了,给作物供应再多养分也没有用。为维持和提升土壤健康,作为土壤肥料工作者,我们团队早在15年前把解决土传病害这一国家重大需求列为重要研究方向,力争解决这一难题。”沈其荣教授告诉记者。
团队徐阳春教授和韦中博士负责的微生态与根际健康实验室重点关注由青枯菌(Ralstoniasolanacearum)引起的土传青枯病。青枯菌在土壤中存活时间长,能够侵染番茄、茄子、辣椒、烟草、生姜、花生等400多种植物,常导致作物减产,甚至绝收。韦中博士向记者介绍,传统化学农药和熏蒸等方法短期内见效快,但病原菌容易形成耐药性;再加上农药和熏蒸剂靶向性不强,在杀灭病原菌的同时也破坏了土壤正常的微生物群落,危及到土壤微生物的生态功能,很可能导致病原菌二次侵染时造成更大危害。
那么是否能找到既能精准猎杀土壤病原菌,又不破坏土壤微生物群落结构和生态功能的环境友好型措施呢?这是可持续农业发展亟需的土传病害防控技术:“精准治疗+生态友好”。2014年5月,在首次来万象城访问的Ville PetriFriman博士医学研究工作的启发下,韦中博士和团队一年级直博生王孝芳把目光聚焦到“噬菌体”这一特殊土壤微生物上。

噬菌体精准调控病原菌-根际菌群互作图
据了解,噬菌体是一类专性侵染细菌的病毒,在环境中普遍存在,其数量级可达109/g土。噬菌体对宿主细菌具有高度侵染特异性,可以实现对特定病原菌的精准裂解,并且能够动态压制病原菌数量。目前,国内外不少学者在医学、养殖、果蔬保鲜、农业病害防控等领域做了不少尝试。土壤环境复杂,噬菌体疗法在土传细菌性病害防控中的效果还不稳定。最重要是的,噬菌体在土壤中抑制土传病原菌的作用机制还没有阐明清楚。
为解决这些问题,实验室首先从广西、江苏、浙江和江西不同地区分离到1000多株病原青枯菌,并筛选到能高效裂解病原菌的噬菌体。其次,根据噬菌体的来源和侵染特性等选择了4株噬菌体为材料,组合成不同丰富度的噬菌体组合,以提高噬菌体疗法的效果。最后通过温室和大田研究,发现噬菌体组合能够显著降低青枯病的发生。
为什么噬菌体组合能有效防控土传青枯病呢?该成果发现噬菌体组合处理根际病原青枯菌数量显著降低,并且组合多样性越高,病原菌成功突变抵御噬菌体的概率越低。即便有一些青枯菌成功突变、残存了下来,但它们的生长显著减缓,这说明它们与土壤中其它微生物竞争的能力减弱,再次侵染作物根系的能力会下降。因此,噬菌体组合猎杀并致弱病原菌是其在根际发挥作用的一个重要机制。
当大量病原青枯菌被猎杀时,宿主相关微生物群落发生了什么变化呢?这种变化对宿主健康有利吗?这是噬菌体疗法领域必须回答的问题,既涉及到生态风险,也涉及到作用机制。“我们发现噬菌体组合显著改变了根际细菌群落结构,细菌群落多样性随噬菌体组合多样性的增加而增加,说明这种影响是积极的。”王孝芳博士说。
细菌群落为什么发生了这么大的改变,是不是噬菌体也能侵染土壤中其它细菌?答案是否定的,从土壤中分离了400株细菌,青枯菌噬菌体都不能侵染,这说明了噬菌体的侵染特异性很强。
那么,是不是因为噬菌体大量猎杀病原青枯菌,释放出大量空间和资源,其他微生物又占据这些空间和资源,这样土壤微生物群落结构就发生了变化呢?王孝芳博士生很快给出了答案:单独接种噬菌体对土壤微生物群落扰动很小,但是接种病原青枯菌会导致土壤群落结构发生巨变,并且多样性显著下降。不过,这种影响可以被噬菌体修复,被破坏的微生物群落多样性可以恢复提升到原有水平。
噬菌体裂解病原青枯菌形成的噬菌斑
深入分析发现并不是所有的土壤微生物都有机会重新获得被噬菌体释放出的空间和资源,细菌群落中那些竞争能力强(如产抑菌物质能力强)的一类物种似乎在群落结构调整中获得了优势,它们的丰度显著增加,可能进一步提高了群落的抑病能力。这些竞争能力强的微生物群体可能与噬菌体一起共同抵御病原菌的再次入侵,有效维持了作物的健康。
沈其荣教授向记者解释,这一发现表明噬菌体不仅可以“专性猎杀”和“精准靶向”病原菌,降低其生存竞争能力;同时还能够重新调整根际土壤菌群的结构,恢复群落多样性,增加群落中拮抗有益菌的丰度。这就相当于,不仅找到了精确猎杀病原菌的“狙击手”,同时还触发了根际防御体系,让打垮的根际菌群又组建了一支“防御军团”!这将为应用推广噬菌体疗法作为精准靶控、生态安全的土传病害防治措施提供重要的理论依据。
王孝芳博士和国家自然科学基金优秀青年项目获得者韦中博士为共同第一作者,沈其荣教授、韦中博士以及农业资源与环境学科生物学研究创新引智(111)基地专家英国约克大学Ville-Petri Friman博士为共同通讯作者,荷兰乌特勒支大学AlexandreJousset博士、徐阳春教授、王佳宁博士生、杨可铭博士生参与了这一工作。
据了解,近年来,万象城awcsport官网微生态与根际健康实验室依托农业资源与环境国家双一流学科,在973项目、国家自然科学基金、国家重点研发计划和江苏省自然科学基金等项目资助下,围绕根际微生态与土传病害防控这一重大问题,在揭示抑病型土壤微生物区系形成机制、菌群互作机制与益生菌群构建和抑病型土壤微生物群落调控等方面取得重要突破。相关工作在Nature Biotechnology、Nature Communications、Science Advances,Ecology Letters、mBio、Environ Microbiol和Soil BiolBiochem等国际著名期刊发表。

阅读次数:8735
【 转载本网文章请注明出处 】